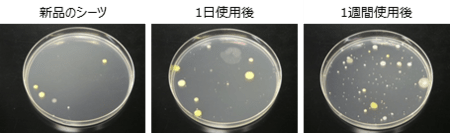
f:id:mashley_slt:20190512213246p:plain f:id:mashley_slt:20190512213246p:plain

ヒソヒソ…

みんな何話してるの?
ベア「あ!姐さん!い、言いにくいんすが
夫婦喧嘩してるんすか?」

は?
ポニ「だって最近嫁氏は客間2
ワクワクさん(夫氏)は客間1に寝てる!」

ああ、それはこの時期のせいだね。
3月から5月くらいにかけて
ワクワクさんはイビキがひどい!
夜中に起きちゃうから
お互いのために納得して
別々に寝ているんだよ。

多分花粉とかPMとかアレルギー反応だろうね…
だから仲が悪いわけじゃないよ。
ベア「よかったっす!!MS家の危機かと…」
ポニ「そういやMS家にはベッドが3つあるね」

寝室のは家できた時に買ったけど
後の2つは違うよ。
客間1のはワクワクさんが実家で
使っていたフランスベッド 。

客間2は結婚前に友達から
もらったニトリさん。

もう10年近く使ってるね。
ポニ「そんなに長く使えるの?」

物によるけどちゃんと手入れすれば
マットレスは長持ちするよ。
じゃあ前回はマットレスの選び方だったから
今回はお手入れの仕方ね!

マットレスは
他の家具とは違う。

消耗品だ。
椅子やテーブルは手入れすれば
50年でも100年でももつけど
マットレスはそうもいかない。

品質の幅がすごくあって
数年でダメになるものもあれば
10年前後持つものもある。
絶対ではないけどいいものでも
大体10年前後と言われている。
何がマットレスをダメにするのか?

「ヘタリ」と「カビやダニ」だ。
ベア「ヘタリっても使えばいいじゃないっすか!」

体に合わないマットレスは
負担がかかり健康を害する。
例えばずっと使っていて何もしないと
同じ部分がへたってくる。
そのまま使い続ければ寝返りが打ちづらく
腰痛や肩こりも起こり眠りも浅い。

実際嫁氏は実家のベッドを何もしなかった。
昔は今よりずっと肩こりだったよ…
カビやダニも体に悪い。
昔泊まった海外のホテルで起きたら
お腹が痒くて真っ赤になった…

あれ多分ダニだったんだろうね…
それとダニでなくても不潔にすると
肌荒れの原因にもなる。
「ヘタリ」も「ダニカビ」も起きてしまうと
元に戻すのは難しい。
だからそうならないように
暮らしの中でのお手入れが必要。

まずそもそもマットレスは
品質が悪いものはヘタリやすい。
すでにへたっているものを
ここでやる方法を試しても
うまくいかない可能性もある。
マットレスを水平に見たり
横になってみてヘタリがあるなら
お手入れよりとり替え時かも。

その場合信頼できる家具屋さんに
相談する方がいいと思う。
またマットレスによっては
特別な手入れが必要なものも。
その場合も同様に相談を。
ただ問題ないマットレスは
お手入れすることで
長持ちする可能性がある。

じゃあお手入れの期間ごとに実践。
まず「毎日」編。
これは何かするっていうより
マットレスの環境づくり。

それは湿気対策。
ダニやカビ防止になる。
マットレスはそもそも日本の暮らしから
生まれたものでない。
湿気の多い環境でマットレス
を使うなら環境づくりが必要。
まずはベッドフレームに注目。

壁にぴったりはくっつけず
少しでも隙間がある方がいい。
さらに湿気が多いお家なら
床に湿気取りを置くのも有効。
MS家は前の家では置いていたけど
今は置いていない。
なぜなら今の家の壁は全て珪藻土で
湿度が低くむしろ乾燥気味だから。

↓珪藻土について
あと防水加工のシーツを使う
方法もある。
これは清潔さを保ち
カビダニ対策になる。
①シーツと敷きパッドの洗濯
みなさんはシーツが
どのくらい汚いか
ご存知だろうか?
これはP&Gの実験。
(PR Wireより)
実験によると1週間でシーツは
便座より菌が多くなる。

そんな中で眠ると肌が弱い人は
肌荒れを起こす可能性もある。
つまり少なくとも1週間に
1回はシーツを洗濯したほうがいい。
敷きパッドは数週間に一回でも
いいかもしれないけどMS家は一応洗濯。

②マットレスの換気
シーツを洗った時にマットレスを
こういう状態にしている。

普段壁や床から離していても
少しでも換気することが
カビダニ対策になる。
あと天日干しする時は注意。
それが向かないマットレスもある。
ウレタンは天日干しで
劣化することもあるから。
定期的な対策で「ヘタリ」を回避。
その方法とはマットレスの
配置換え。

人は寝る時だいたい同じような姿勢
同じような場所に寝る。
そうすると体重がよりかかるところに
ヘタリが生まれてくる。

それを分散させるとヘタリが緩和され
マットレスは長持ちしやすい。
ということでMS家は3ヶ月に1回
マットレスの位置を変えている。

今の所ヘタリが見られない。
ポニ「でもさ数ヶ月置きなんて
忘れちゃうでしょ?」

昔は時々忘れて思い出しては
やっている感じだった。
でも今は違う。
マステとペンを用意!!
マットレスの配置換え日と
どう移動したかを書いて貼る。

MS家は定期的にやってるから
そろそろかなって思ったら
シーツめくってみればわかる。

もし配置換えの習慣がないなら
カレンダーに書いておくのもいい。
それくらいマットレスの配置換え
ってヘタリ防止に大事なんだよ。
ただ配置換えについては注意あり。
配置換えは上下裏表行う。

だけどマットレスによっては
裏表で詰め物の素材を変えて
裏返せないものもある。

そういう時は上下だけ行うのがいい。
MS家のリビングのデイベッドも
裏返すとスプリングだから不可…

こんな感じでMS家は
特別なことはしていない。

ただ
日々の環境づくり
1週間ごとのお手入れ
数ヶ月ごとの配置換え
それをするだけで
2つのマットレスは古いけど元気。

10年過ぎて状態次第では
買い換えなければいけないかも。
逆にヘタリやカビダニがなければ
さらにもう少し使えるかも。
期間ごとのちょっとした工夫で
彼らは天寿を全うできるかもしれない。
マットレスの元気は
使う人の元気も生み出す。

ぜひお家でのお手入れで
長生きさせてあげてください。
今日も嫁氏とワクワクさんは
それぞれの部屋でのんびり。

マットレスが心地いいと
過ごしやすい。

ベア「じゃあしばらく
僕らが寝室占領だー!」

飛び跳ねは禁止ね!!